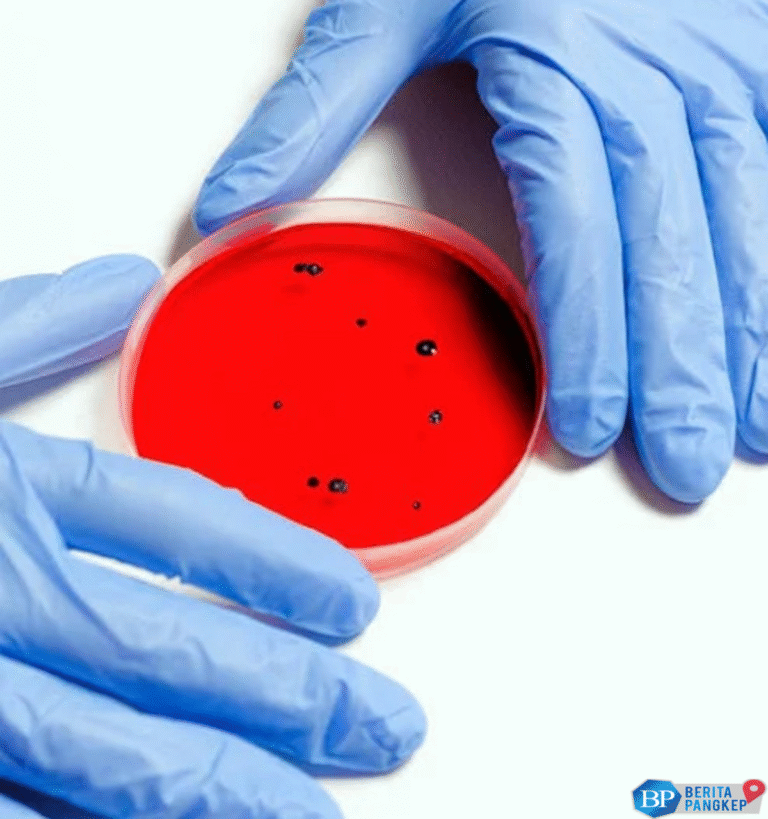
ironi-negara-kaya-minyak-wabah-korela-tembus-20-ribu

Jakarta, PANGKEP NEWS Angola telah melaporkan lebih dari 20.000 kasus kolera sejak awal tahun ini. Menurut laporan...
Hari: 14 Mei 2025
Pemilik Emas Dapat Bernafas Lega, Harga Emas Mengalami Peningkatan Jakarta – Harga emas dunia kembali menunjukkan penguatan...
Investor Asing Ramai-ramai Lepas 10 Saham Jelang Libur Panjang Jakarta, PANGKEP NEWS – Menjelang libur panjang, Indeks...
Jakarta, PANGKEP NEWS Di Indonesia, para pengusaha mengidentifikasi berbagai masalah yang berkontribusi pada perlambatan pertumbuhan ekonomi negara....
Gencatan Senjata Terwujud, Sekolah di Kashmir Dibuka Lagi Setelah berlangsungnya kesepakatan gencatan senjata antara India dan Pakistan,...
Trump Resmi Hapus Semua Sanksi untuk Suriah Jakarta, PANGKEP NEWS – Presiden Amerika Serikat (AS) Donald Trump...
BGN Siap Tanggung Pengobatan Siswa yang Keracunan Menu MBG Jakarta – Badan Gizi Nasional (BGN) berkomitmen untuk...
BGN Berkomitmen Menanggung Biaya Pengobatan Ratusan Pelajar Keracunan MBG BGN menyatakan kesiapannya untuk menanggung biaya pengobatan bagi...